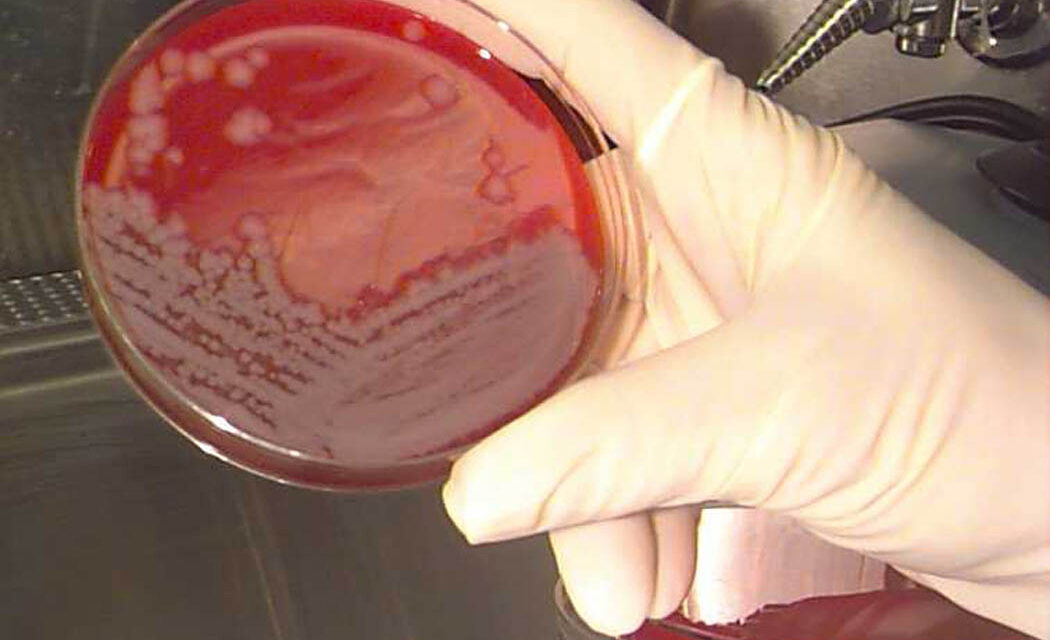
Lépfenét diagnosztizáltak egy páciensnél Magyarországon

Egy 70 éves békés vármegyei férfinál igazoltak bőranthrax-megbetegedést, derült ki a Nemzeti Népegészségügyi és Gyógyszerészeti Központ (NNGYK) Járványügyi és Infekciókontroll Főosztályának jelentéséből, ami az október 27. és november 2. között időszakot vizsgálta, írja a Telex.
Miután az NNGYK-nak jelezték a gyanút, a járványügyi hatóság azonnal megkezdte a kivizsgálást, majd kiderült, hogy a 70 éves férfi azután betegedett meg, hogy haszonállattal érintkezett. A férfi a panaszok kezdetét megelőzően marhát vágott, és az állat feldolgozása során keze megsérült.
Támogassa a független vajdasági magyar újságírást!
Havi 5 euróért reklámmentesen olvashatja portálunkat és a PLUSZ rovat tartalmait.
Tovább az előfizetési oldalra: Kártyás előfizetés (ÚJ) – Banki átutalás vagy Paypal
Ezután értesítették az élelmiszerlánc-felügyeleti szervet, felkutatták a kontaktokat, és megkezdődött a járványügyi megfigyelésük.
A lépfene baktérium (Bacillus anthracis) okozta állatbetegség, amely egyben fontos zoonózis, azaz állatról emberre terjedő betegség is. A bőrlépfene a bőr megsebzésével alakul ki. Először egy piros göb (papula) keletkezik, amelyből később hólyag jön létre. A hólyag felfakad, és sötétbarna vagy fekete pörk képződik (pokolvar). A pörk környéke vizenyősen-véresen beszűrődik, olvasható a Nébih honlapján. Az időben felfedezett lépfene antibiotikum (elsősorban penicillin) kezeléssel jól gyógyítható.
B. anthracis-szal fertőzött vér egy laboratóriumi üveglapon, biztonsági fülkében (Illusztráció/Wikipédia)
Itt az év ajánlata: te nyugodtabb, mi még jobbak leszünk!
 A visszajelzések alapján három dolog idegesít a honlapon:
A visszajelzések alapján három dolog idegesít a honlapon:
- a felugró reklámok,
- az, hogy nem tudod végigolvasni az előfizetőknek járó cikket,
- a mellégépelések.
A mi problémánk pedig az, hogy nem tudunk még több saját anyagot előállítani, mert a mintegy húsz önkormányzat nulla dinárt hagyott jóvá a beadványainkra, és a Magyar Nemzeti Tanács – a pártházból érkező, mondvacsinált okokra hivatkozva – évek óta nem javasolja támogatásra a pályázatainkat.
Segítsünk egymáson! Napi húsz dinárért (0,17 euró) legyél a Szabad Magyar Szó előfizetője, így megszabadulsz a felugró reklámoktól, elolvashatod a Plusz rovatban megjelenő cikkeket, és nem mellékesen ezzel is hozzájárulsz, hogy továbbra is a Szabad Magyar Szó legyen a legolvasottabb vajdasági magyar honlap és még több helyi témáról számoljunk be!
U. i. Ha kétszáznál több előfizetőnk lesz, bizisten, még egy olvasószerkesztő alkalmazását is megfontoljuk!